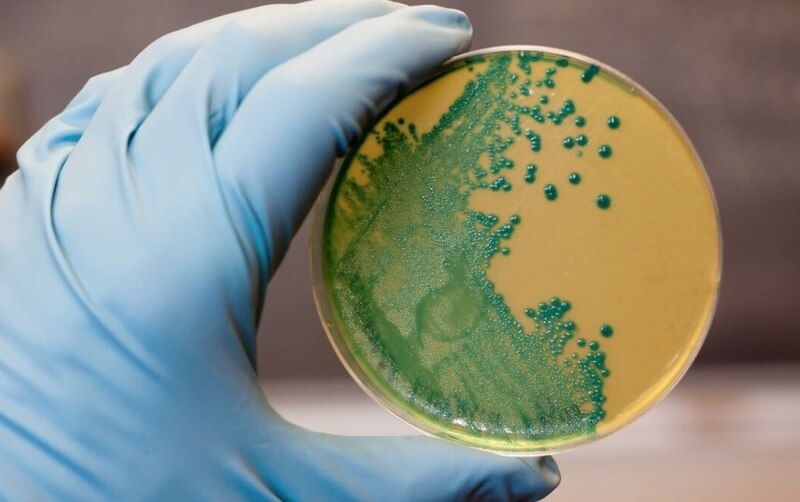
La listeria, una bacteria que provoca mucha incertidumbre

Identifican el gen que influye en el desarrollo de la diabetes tipo 2
Los mexicanos se encuentran entre los habitantes de la Tierra con más predisposición a sufrir esa enfermedad metabólica, la segunda causa de mortalidad en México.
Leer más...
Obesidad y hambre, los dos grandes males de América Latina
La obesidad y el hambre son los dos mayores males que padece América Latina y el Caribe, según un informe publicado este lunes por la OCDE y la FAO, que denuncia una grave situación alimentaria o de mala nutrición en toda la región, así como un aumento de la población en situación de inseguridad alimentaria.
Leer más...
Para 2050 se necesitará un 80% más de alimentos
La falta de tierra cultivable obliga a agricultores a buscar otras alternativas, como la de la reproducción acelerada.
Leer más...
La obesidad competiría con el tabaquismo como principal causa de cáncer
La obesidad competiría con el tabaco como una de las primeras causas de cáncer y ya es responsable de más casos de tumores de intestino, riñón, ovario e hígado que los cigarrillos, según alerta Cancer Research UK (CRUK), la principal organización benéfica del cáncer del Reino Unido.
Leer más...
El café, el aliado menos pensado en la lucha contra la obesidad
Un reciente estudio reveló que tomar una taza al día de esa infusión puede estimular la "grasa marrón", encargada de controlar las grasas, y fundamental para prevenir el exceso de peso y la diabetes.
Leer más...
La fibromialgía estaría relacionada con la flora intestinal
La abundancia o, todo lo contrario, la ausencia de ciertas bacterias, marcan la gravedad de los síntomas.
Leer más...
El consumo de alimentos ultraprocesados comporta un 62% más de riesgo de muerte
Ingerir más de cuatro raciones diarias de alimentos ultraprocesados incrementa en un 62 % el riesgo de mortalidad, independientemente de otras causas. Es más, por cada ración adicional el riesgo crece un 18 %.
Leer más...
Argentina pone en marcha el Plan ASÍ para intentar detener la obesidad infantil
El gobierno argentino, a través del Ministerio de Salud y Desarrollo Social de la Nación, puso en marcha el Plan Nacional de Alimentación Saludable en la Infancia y la Adolescencia, Plan ASÍ, una iniciativa que tiene por objetivo detener la epidemia creciente de sobrepeso y obesidad en niños, niñas y adolescentes (2019-2023). La iniciativa, que contempla medidas educativas, comunicacionales y regulatorias basadas en evidencia científica, fue publicada en el Boletín Oficial.
Leer más...
La listeria, una bacteria que provoca mucha incertidumbre
Un estudio sobre la situación epidemiológica de la listeriosis en España, elaborado por investigadores del Instituto de Salud Carlos III y del Hospital Universitario Ramón y Cajal de Madrid, y publicado en 'Eurosurveillance', evidencia un incremento de hospitalizaciones por listeriosis.
Leer más...
Cómo los ejercicios de fuerza podrían controlar la diabetes en individuos obesos
Una investigación realizada en la Universidad de Campinas (Unicamp) y publicada en Journal of Endocrinology, mostró que la práctica de ejercicios físicos de fuerza como los de musculación podría ser capaz de reducir la cantidad de grasa acumulada en el hígado –una condición a la que también se la conoce con el nombre de esteatosis hepática– y mejorar el control de la glucemia en individuos obesos y diabéticos en un corto lapso de tiempo, incluso antes de que se produzca una pérdida de peso significativa.
Leer más...
Argentina prepara su nueva forma de etiquetado
El secretario de Salud de la Nación, Adolfo Rubinstein, dijo si bien no hay una fecha definida para el lanzamiento del etiquetado frontal en el país, los avances fueron importantes en los últimos meses y se espera que antes de fin de año pueda comenzar a implementarse.
Leer más...
Saltearse el desayuno podría tener una causa genética
Por primera vez, investigadores hallaron un componente genético en el hábito de hacer o no la primera comida del día.
Leer más...
Un alto consumo de fibra en el embarazo reduciría el riesgo de celiaquía en niños
Un consumo alto de fibra durante el embarazo se relacionaría con menor riesgo de enfermedad celíaca en los niños, según una nueva investigación presentada en la Reunión Anual de la Sociedad Europea de Gastroenterología, Hepatología y Nutrición Pediátrica (ESPGHAN).
Leer más...
Obesidad en México: según expertos 3 de cada 10 personas con sobrepeso padecen algún trastorno mental
La Encuesta Nacional de Salud y Nutrición (ENSANUT) de Medio Camino del Instituto de Salud Pública, detalló que el 75.6% de las mujeres mayores de 20 años vive con un grado de sobrepeso u obesidad.
Leer más...
Comer carne roja aumenta hasta en un 13 % el riesgo de muerte prematura y ciertos tipos de cáncer: asegura nuevo estudio
Además se le ha relacionado con diabetes tipo 2, enfermedades cardiovasculares, insuficiencia cardíaca, hipertensión, entre otras.
Leer más...
¿El entrenamiento a intervalos de alta intensidad es una bala mágica para la pérdida de masa grasa?
Recientemente, se ha publicado una revisión sistemática y un meta-análisis sobre el entrenamiento de intensidad moderada y entrenamientos de intervalos de alta intensidad (HIIT) en relación con la pérdida de grasa corporal en la revista British Journal of Sports Medicine.
Leer más...
Estudio: Dormir con la TV encendida puede causar obesidad
Dormir viendo la televisión o con las luces encendidas podría desordenar tu metabolismo y provocar un aumento de peso o incluso obesidad, sugieren los resultados preliminares de un estudio estadounidense publicado el lunes.
Leer más...
Millones de muertes cardiovasculares atribuidas al consumo insuficiente de frutas y verduras
Los hallazgos preliminares de un nuevo estudio revelan que el consumo insuficiente de frutas y verduras puede representar millones de muertes por enfermedades cardíacas y accidentes cerebrovasculares cada año. El estudio estimó que aproximadamente 1 de cada 7 muertes cardiovasculares podría atribuirse a no comer suficiente fruta y 1 de cada 12 muertes cardiovasculares podría atribuirse a no comer suficientes verduras.
Leer más...
Los latinoamericanos son los mayores consumidores de bebidas azucaradas en el mundo
México y Colombia encabezan la lista que incluye las llamadas "bebidas energéticas", jugos de fruta, limonadas y otras "aguas frescas".
Leer más...
Una dieta baja en grasa reduce el riesgo de muerte por cáncer de mama en postmenopáusicas
Las mujeres postmenopaúsicas que tienen una dieta equilibrada y baja en grasas tienen un 21% menos de riesgo de muerte por cáncer de mama, en comparación con aquellas que llevan comen más grasas, según los resultados de un ensayo clínico realizado por Women's Health Initiative (WHI), y que han sido presentados en el Congreso de la Sociedad Americana de Oncología, que estos días se celebra en Chicago, Estados Unidos.
Leer más...
